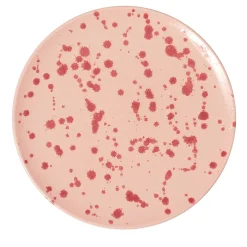
Carola fra i Trulli Piatto decorativo in ceramica rosa e borgogna> Piatti Decorativi

Candelieri E Portacandele
Carola fra i Trulli Portacandele Trullo bianco e nero> Candelieri E Portacandele
Candelieri E Portacandele
Carola fra i Trulli Portacandele Trullo Caramello e Arancio> Candelieri E Portacandele
Candelieri E Portacandele
Carola fra i Trulli Portacandele Trullo Rosa e Borgogna> Candelieri E Portacandele
Candelieri E Portacandele
Carola fra i Trulli Portacandele Trullo verde e acquamarina> Candelieri E Portacandele
Candelieri E Portacandele
Carola fra i Trulli Trullo Portacandele lilla e viola> Candelieri E Portacandele
Candelieri E Portacandele
Carrara Home Design Portacandele in marmo bianco di Carrara> Candelieri E Portacandele
Candelieri E Portacandele
Carrara Home Design Portacandele in marmo grigio Bardiglio> Candelieri E Portacandele
Candelieri E Portacandele
Carrara Home Design Portacandele in marmo nero Marquina> Candelieri E Portacandele